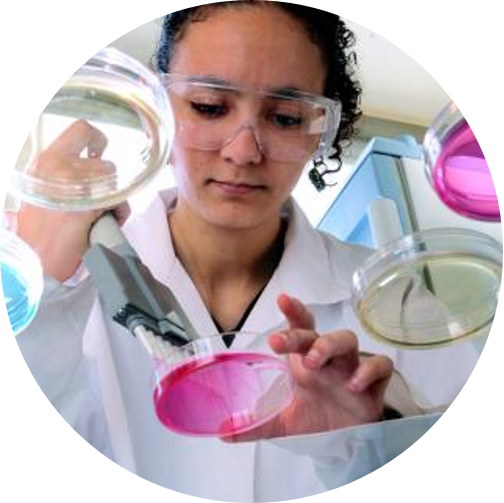

El cáncer se ha convertido en uno de los grupos de enfermedades más importantes y con mayor repercusión para la ciudadanía. Identificar los principales agentes cancerígenos resulta fácil para la gran mayoría: tabaco, alcohol, luz solar, contaminación ambiental, sedentarismo y rayos X, entre otros, son los más relacionados con distintos casos de cáncer. Tampoco resulta complicado conocer que el ejercicio físico, una dieta equilibrada, no fumar y, en general, mantener una vida con hábitos saludables son la mejor forma y más eficaz de combatir, desde la prevención, esta enfermedad.
Sin embargo, cuando el agente cancerígeno forma parte de la actividad laboral, nuevos factores entran en juego, desde una menor información o consciencia de su peligrosidad, hasta la dificultad para su eliminación en un proceso o actividad productiva. Una primera consecuencia de esta concurrencia de nuevos factores, que se unen a los ya apuntados con anterioridad, es la dificultad de concretar la carga de cáncer atribuible al trabajo, si bien se estima que es la principal causa de muerte relacionada con la actividad laboral en la Unión Europea.
juego, desde una menor información o consciencia de su peligrosidad, hasta la dificultad para su eliminación en un proceso o actividad productiva. Una primera consecuencia de esta concurrencia de nuevos factores, que se unen a los ya apuntados con anterioridad, es la dificultad de concretar la carga de cáncer atribuible al trabajo, si bien se estima que es la principal causa de muerte relacionada con la actividad laboral en la Unión Europea.
El conocimiento del número de cánceres atribuibles al trabajo, así como el cálculo de su coste sanitario, además de poner de manifiesto la envergadura real del problema, evitando la infradeclaración de casos, ha de permitir la asignación adecuada de recursos sanitarios, humanos y materiales, así como el establecimiento de medidas públicas y privadas para su prevención. El informe elaborado por el Ministerio de Sanidad, “Carga de cáncer atribuible al trabajo y su coste sanitario en España en 2015”, revela que en Castilla – La Mancha en el caso de los hombres, el mayor número de ingresos se debió a cánceres de pulmón, vejiga y colon; por su parte, las neoplasias de mama, mesoteliomas y los cánceres de pulmón, fueron más frecuentes en mujeres.

Por tanto, además de seguir las recomendaciones generales para la prevención del cáncer, la población trabajadora ha de ser objeto de acciones y medidas preventivas adicionales, que se ajusten a las características y condiciones de su puesto de trabajo y actividad.
LA PREVENCIÓN DE RIESGOS EN EL ÁMBITO LABORAL
En preciso remarcar que la prevención de los riesgos frente a agentes cancerígenos forma parte de la actividad preventiva de la empresa. Es decir, es un proceso en el que todas las partes están implicadas: la empresa, en cumplimiento de su deber de protección; el personal especializado del servicio de prevención, dada la especial naturaleza y complejidad de este tipo de riesgos; y la población trabajadora, directamente o a través de sus representantes, demandando y, a su vez, adoptando, las medidas preventivas y de formación e información más adecuadas para la prevención del riesgo.
 Dejando al margen la exposición a fibras de amianto, agente cancerígeno que dispone de reglamentación propia, el RD 665/1997, de 12 de mayo, es la norma de obligado cumplimiento para prevenir este tipo de riesgos en el ámbito laboral. Norma que se actualiza con relativa frecuencia, a fin de ir dando cabida a las sustancias, mezclas y procedimientos con la condición de cancerígenos. Así, por ejemplo, en 2015 se incorporó la exposición a polvo de maderas duras, tanto de origen tropical como otras variedades (cerezo, haya, roble) de localización más próxima en nuestro territorio. En 2020, la exposición al polvo respirable de sílice cristalina, afectando no solo a minería, sino a múltiples oficios de la construcción, industria cerámica y otros. Y hace unos días, el Consejo de Ministros de 15 de junio de 2021 ha aprobado la inclusión de, entre otras, la exposición inhalatoria a emisiones de motores diésel y la exposición cutánea a aceites minerales utilizados en la lubricación y refrigeración de motores.
Dejando al margen la exposición a fibras de amianto, agente cancerígeno que dispone de reglamentación propia, el RD 665/1997, de 12 de mayo, es la norma de obligado cumplimiento para prevenir este tipo de riesgos en el ámbito laboral. Norma que se actualiza con relativa frecuencia, a fin de ir dando cabida a las sustancias, mezclas y procedimientos con la condición de cancerígenos. Así, por ejemplo, en 2015 se incorporó la exposición a polvo de maderas duras, tanto de origen tropical como otras variedades (cerezo, haya, roble) de localización más próxima en nuestro territorio. En 2020, la exposición al polvo respirable de sílice cristalina, afectando no solo a minería, sino a múltiples oficios de la construcción, industria cerámica y otros. Y hace unos días, el Consejo de Ministros de 15 de junio de 2021 ha aprobado la inclusión de, entre otras, la exposición inhalatoria a emisiones de motores diésel y la exposición cutánea a aceites minerales utilizados en la lubricación y refrigeración de motores.
La empresa, por tanto, ha de identificar los agentes cancerígenos existentes en su proceso productivo y, a continuación, realizar la evaluación de riesgos, desde un enfoque de prudencia extrema: es decir, siempre que sea técnicamente posible, la medida obligatoria será la sustitución del producto cancerígeno o proceso que lo genere por otro que no sea peligroso o, cuanto menos, que lo sea en menor medida. Ha de tenerse en cuenta que, a diferencia de otros agentes químicos en los que los efectos tóxicos dependen de la dosis, en el caso de los cancerígenos, los referidos efectos tienen una componente probabilística, es decir, pueden producirse aún en el caso de dosis de baja exposición.
Si la sustitución del agente no es viable, el proceso productivo deberá realizarse en sistema cerrado o, en último término, se aplicará el principio ALARA: reducción de la exposición al nivel técnicamente más bajo posible.
último término, se aplicará el principio ALARA: reducción de la exposición al nivel técnicamente más bajo posible.
Mención especial requiere la prevención de la exposición a este tipo de agentes, así como a los calificados como mutágenos, para trabajadoras en situación de embarazo o de lactancia natural: en todo caso, no podrán realizar actividades en las que la evaluación de riesgos concluya que existe riesgo de exposición que pone en peligro su salud, la del feto o la del lactante.
Desde un punto de vista práctico, el etiquetado de los envases de productos facilita información que permite identificar la presencia de agentes cancerígenos: la indicación H350 indica que el producto está clasificado como carcinógeno para las personas, en tanto que la indicación H351 señala que dicho producto es sospechoso de ser, de igual modo, carcinógeno. En esta línea, las notaciones H360 y H361 señalan, respectivamente, la clasificación como producto que puede dañar la fertilidad o el feto, o que es sospechoso de producir estos daños. De manera adicional, la empresa ha de recabar la ficha de datos de seguridad de todos los productos utilizados en su proceso productivo o actividad, dado que estos documentos, al igual que el etiquetado, amplían la información, facilitando Indicaciones de peligro (frases H) y Consejos de prudencia (frases P).
La posesión y difusión de esta información básica entre la población trabajadora, así como el trabajo especializado de los servicios de prevención de las empresas, se constituyen como el punto de partida de una adecuada gestión de la prevención de este tipo de agentes peligrosos.
En el marco de las actuaciones de asesoramiento técnico, control y vigilancia que lleva a cabo el personal técnico de los Servicios de Seguridad y Salud Laboral e Inspección de Trabajo y Seguridad Social, se han programado actuaciones específicas en actividades como industria de la madera y talleres de vehículos, que se unen a la acción habitual desarrollada en los trabajos con exposición a fibras de amianto.
JORNADA TÉCNICA TELEMÁTICA
Asimismo, con el fin de facilitar y contribuir a la prevención de estos riesgos en el ámbito laboral, la Viceconsejería de Empleo, Diálogo Social y Bienestar Laboral, en el marco de las acciones de difusión y divulgación de la cultura preventiva, así como de la prevención de enfermedades profesionales, del Acuerdo Estratégico para la Prevención de Riesgos Laborales en Castilla – La Mancha, 2017-2021, ha programado una jornada técnica telemática con la participación de personal experto del Ministerio de Sanidad y del Instituto Nacional de Seguridad y Salud en el Trabajo, abierta a la participación de las personas y empresas interesadas en ampliar su conocimiento sobre esta materia.
 La información sobre la jornada, de carácter gratuito, está disponible en la página web de Seguridad Laboral de Castilla – La Mancha (www.seguridadlaboral.castillalamancha.es).
La información sobre la jornada, de carácter gratuito, está disponible en la página web de Seguridad Laboral de Castilla – La Mancha (www.seguridadlaboral.castillalamancha.es).












